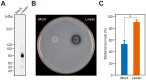

Cell wall-anchored nuclease of Streptococcus sanguinis contributes to escape from neutrophil extracellular trap-mediated bacteriocidal activity
- PMID: 25084357
- PMCID: V体育平台登录 - PMC4118848
- DOI: 10.1371/journal.pone.0103125
Cell wall-anchored nuclease of Streptococcus sanguinis contributes to escape from neutrophil extracellular trap-mediated bacteriocidal activity
"VSports" Abstract
Streptococcus sanguinis, a member of the commensal mitis group of streptococci, is a primary colonizer of the tooth surface, and has been implicated in infectious complications including bacteremia and infective endocarditis. During disease progression, S. sanguinis may utilize various cell surface molecules to evade the host immune system to survive in blood. In the present study, we discovered a novel cell surface nuclease with a cell-wall anchor domain, termed SWAN (streptococcal wall-anchored nuclease), and investigated its contribution to bacterial resistance against the bacteriocidal activity of neutrophil extracellular traps (NETs). Recombinant SWAN protein (rSWAN) digested multiple forms of DNA including NET DNA and human RNA, which required both Mg(2+) and Ca(2+) for optimum activity. Furthermore, DNase activity of S. sanguinis was detected around growing colonies on agar plates containing DNA. In-frame deletion of the swan gene mostly reduced that activity VSports手机版. These findings indicated that SWAN is a major nuclease displayed on the surface, which was further confirmed by immuno-detection of SWAN in the cell wall fraction. The sensitivity of S. sanguinis to NET killing was reduced by swan gene deletion. Moreover, heterologous expression of the swan gene rendered a Lactococcus lactis strain more resistant to NET killing. Our results suggest that the SWAN nuclease on the bacterial surface contributes to survival in the potential situation of S. sanguinis encountering NETs during the course of disease progression. .
Conflict of interest statement
Figures

References
-
- Hamada S, Slade HD (1980) Biology, immunology, and cariogenicity of Streptococcus mutans . Microbiol Rev 44: 331–384. - "VSports手机版" PMC - PubMed
-
- Moreillon P, Que YA (2004) Infective endocarditis. Lancet 363: 139–149. - PubMed (VSports手机版)
-
- Strom BL, Abrutyn E, Berlin JA, Kinman JL, Feldman RS, et al. (1998) Dental and cardiac risk factors for infective endocarditis. A population-based, case-control study. Ann Intern Med 129: 761–769. - PubMed (V体育2025版)
-
- Dyson C, Barnes RA, Harrison GA (1999) Infective endocarditis: an epidemiological review of 128 episodes. J Infect 38: 87–93. - "VSports最新版本" PubMed
Publication types (VSports在线直播)
MeSH terms
- "VSports在线直播" Actions
- Actions (VSports app下载)
- VSports最新版本 - Actions
- "VSports最新版本" Actions
- "VSports手机版" Actions
- "VSports最新版本" Actions
- Actions (VSports app下载)
- V体育ios版 - Actions
- Actions (VSports app下载)
- VSports app下载 - Actions
- Actions (V体育官网)
- "V体育2025版" Actions
Substances
- "V体育安卓版" Actions
- Actions (VSports手机版)
LinkOut - more resources
Full Text Sources
V体育官网 - Other Literature Sources
V体育官网 - Miscellaneous

